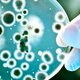
1

-
 Hasta ese momento el mundo de los microorganismos era desconocido, no se sabia nada de esas pequeñas criaturas invisibles para la visión. A partir de ahora se comienza los estudios y investigación de los mismos.
Hasta ese momento el mundo de los microorganismos era desconocido, no se sabia nada de esas pequeñas criaturas invisibles para la visión. A partir de ahora se comienza los estudios y investigación de los mismos. -
 Primera observación de las células. Marcando el comienzo de la teoría celular, que postula "todos los seres vivos están formados por células"
Primera observación de las células. Marcando el comienzo de la teoría celular, que postula "todos los seres vivos están formados por células" -
 Observo y describió por primera vez los microoganimos. Nombrándolos Animaculos; utilizando un microscopio simple de una sola lente. Sus dibujos se identifican como representantes de bacterias y protozoos
Observo y describió por primera vez los microoganimos. Nombrándolos Animaculos; utilizando un microscopio simple de una sola lente. Sus dibujos se identifican como representantes de bacterias y protozoos -
 Sistema de nomenclatura de los organismos. El nombre científico de un organismo vivo es la combinación de dos palabras en latín.
Sistema de nomenclatura de los organismos. El nombre científico de un organismo vivo es la combinación de dos palabras en latín.
Nombre genérico + Nombre especifico -
 Descubrió que aún después de haber calentado liquido nutritivo, ese rápidamente se invadía de microorganismos. Afirmando que los microbios se desarrollaban espontáneamente de los líquidos.
Descubrió que aún después de haber calentado liquido nutritivo, ese rápidamente se invadía de microorganismos. Afirmando que los microbios se desarrollaban espontáneamente de los líquidos. -
 Demostró que los líquidos nutritivos calentados después de haber sellado el frasco no se producía crecimiento microbiano alguno. Needham respondió que la fuerza viral necesaria para la generación había sido destruida por el calor.
Demostró que los líquidos nutritivos calentados después de haber sellado el frasco no se producía crecimiento microbiano alguno. Needham respondió que la fuerza viral necesaria para la generación había sido destruida por el calor. -
 Considerado el padre de la inmunología, probó con éxito la primera vacuna de la historia, que fue la de la Viruela. En 1979 se erradico la viruela en todo el mundo. Su método para prevenir la viruela a logrado salvar millones de vida.
Considerado el padre de la inmunología, probó con éxito la primera vacuna de la historia, que fue la de la Viruela. En 1979 se erradico la viruela en todo el mundo. Su método para prevenir la viruela a logrado salvar millones de vida. -
 La importancia de los microorganismos como causantes de las enfermedades infecciosas no fue bien conocida hasta el siglo XIX. Tradicionalmente se creía que las enfermedades eran consecuencia de fuerzas sobrenaturales.
La importancia de los microorganismos como causantes de las enfermedades infecciosas no fue bien conocida hasta el siglo XIX. Tradicionalmente se creía que las enfermedades eran consecuencia de fuerzas sobrenaturales. -
 Fue un etomólogo y botánico, quien precedió a Lous Pasteur en descubrir que los microorganismos pueden caudar enfermedades (la teoría de los gérmenes). Él descubrió que la "muscardina" o "mal del segno" (una enfermedad del gusano de seda) era causada por un muy pequeño organismo parasítico, un hongo que eventualmente se llamaría Beauveria bassiana en su honor.
Fue un etomólogo y botánico, quien precedió a Lous Pasteur en descubrir que los microorganismos pueden caudar enfermedades (la teoría de los gérmenes). Él descubrió que la "muscardina" o "mal del segno" (una enfermedad del gusano de seda) era causada por un muy pequeño organismo parasítico, un hongo que eventualmente se llamaría Beauveria bassiana en su honor. -
 Ignaz Semmelweis, fue un obstetra húngaro que a mediados del siglo XIX, precediendo los hallazgos de Pasteur y Lister, logró descubrir la naturaleza infecciosa de la fiebre puerperal, logrando controlar su aparición con una simple medida de antisepsia.
Ignaz Semmelweis, fue un obstetra húngaro que a mediados del siglo XIX, precediendo los hallazgos de Pasteur y Lister, logró descubrir la naturaleza infecciosa de la fiebre puerperal, logrando controlar su aparición con una simple medida de antisepsia. -
 Durante este período se realizaron avances rápidos encabezados sobre todo por Pasteir y robert Koch que condujeron al establecimiento de la microbiología como ciencia.
Durante este período se realizaron avances rápidos encabezados sobre todo por Pasteir y robert Koch que condujeron al establecimiento de la microbiología como ciencia. -
 Descubrió que los microorganismos denomiados levaduras convertían los azúcares en alcohol en ausencia de aire. Este proceso, denominado fermentación, se utiliza para elaborar vino y cerveza. La acidez y el deterioro son causados por microorganismos diferentes denominados bacterias.
Descubrió que los microorganismos denomiados levaduras convertían los azúcares en alcohol en ausencia de aire. Este proceso, denominado fermentación, se utiliza para elaborar vino y cerveza. La acidez y el deterioro son causados por microorganismos diferentes denominados bacterias. -
 Desafió la generación espontanea con el concepto de Biogénesis, la afirmación de que las células vivas sólo podían surgir de células vivas preexistentes.
Desafió la generación espontanea con el concepto de Biogénesis, la afirmación de que las células vivas sólo podían surgir de células vivas preexistentes. -
 Con una serie de experimentos demostró que los microorganismos están presentes en el aire y pueden contaminar soluciones estériles pero que el aire por si solo no crea microbios.
Con una serie de experimentos demostró que los microorganismos están presentes en el aire y pueden contaminar soluciones estériles pero que el aire por si solo no crea microbios. -
 La solución al deterioro de vino y cerveza, fue someterlos al calor durante el tiempo suficiente para destruir la mayor parte de las bacterias que causaban dicho deterioro. Este proceso de denomino pasteurización. La demostración de la conexión entre el deterioro de los alimentos y los microorganismos fue un paso fundamental hacia el establecimiento de la relación entre la enfermedad y los microbios.
La solución al deterioro de vino y cerveza, fue someterlos al calor durante el tiempo suficiente para destruir la mayor parte de las bacterias que causaban dicho deterioro. Este proceso de denomino pasteurización. La demostración de la conexión entre el deterioro de los alimentos y los microorganismos fue un paso fundamental hacia el establecimiento de la relación entre la enfermedad y los microbios. -
 Lister, sabia que el fenol (ácido carbonilico) destruía las bacterias de modo que comenzó a tratar las heridas quirúrgicas con una solución de fenol. Esta práctica redujo tanto la incidencia de infecciones y muertes que otros cirujanos la aplicaron de inmediato. Fue uno de los primeros intentos médicos de controlar las infecciones causas por microorganismos, probando de estos causan infecciones en las heridas.
Lister, sabia que el fenol (ácido carbonilico) destruía las bacterias de modo que comenzó a tratar las heridas quirúrgicas con una solución de fenol. Esta práctica redujo tanto la incidencia de infecciones y muertes que otros cirujanos la aplicaron de inmediato. Fue uno de los primeros intentos médicos de controlar las infecciones causas por microorganismos, probando de estos causan infecciones en las heridas. -
 Fue el descubridor de la causa del carbunco, una enfermedad que estaba destruyendo al ganado bovino y ovino en Europa. La bacteria con forma de bastón que ahora conocemos como Bocillus anthracis en la sangre de los animales muestos con carbunco
Fue el descubridor de la causa del carbunco, una enfermedad que estaba destruyendo al ganado bovino y ovino en Europa. La bacteria con forma de bastón que ahora conocemos como Bocillus anthracis en la sangre de los animales muestos con carbunco -
 Koch estableció una secuencia ed pasos experimentales para relacionar directamente un microbio específico con una enfermedad especifica. En la actualidad estos pasos se conocen como postulados de Koch.
Koch estableció una secuencia ed pasos experimentales para relacionar directamente un microbio específico con una enfermedad especifica. En la actualidad estos pasos se conocen como postulados de Koch. -
 Descubrió el modo en que actúan las vacunas. La bacteria que produce el cólera aviario perdía su capacidad de causar enfermedad, después de ser cultivada en el laboratorio durante períodos prolongados. Utilizando el término vacuna para designar a los cultivos de microorganismos avirulentos utilizados para prevenir la enfermedad.
Descubrió el modo en que actúan las vacunas. La bacteria que produce el cólera aviario perdía su capacidad de causar enfermedad, después de ser cultivada en el laboratorio durante períodos prolongados. Utilizando el término vacuna para designar a los cultivos de microorganismos avirulentos utilizados para prevenir la enfermedad. -
 Pasteur vacuna contra la rabia con éxito al niño Joseph Meister
Pasteur vacuna contra la rabia con éxito al niño Joseph Meister -
 Dmitri Iósifovich Ivanovski fue un biólogo ruso, el primer científico en describir las características de una entidad acelular que denominó virus. Informó que el microorganismo causante de la enfermedad del mosaico del tabaco era tan diminuto que atravesaba filtros los bastantes finos como para impedir el paso de todas las bacterias conocidas.
Dmitri Iósifovich Ivanovski fue un biólogo ruso, el primer científico en describir las características de una entidad acelular que denominó virus. Informó que el microorganismo causante de la enfermedad del mosaico del tabaco era tan diminuto que atravesaba filtros los bastantes finos como para impedir el paso de todas las bacterias conocidas. -
 Luego de evaluar centenares de sustancias, halló una gente quimioterápico denominado Salvarsán, un derivado arsenical eficaz contra la silifis.
Luego de evaluar centenares de sustancias, halló una gente quimioterápico denominado Salvarsán, un derivado arsenical eficaz contra la silifis. -
 Durante ese período de intensa producción científica los micoorganismos, mejoraron las técnicas para la realización de estudios microscópicos y de cultivo de microorganismos y desarrollaron vacunas y técnicas quirúrgicas.
Durante ese período de intensa producción científica los micoorganismos, mejoraron las técnicas para la realización de estudios microscópicos y de cultivo de microorganismos y desarrollaron vacunas y técnicas quirúrgicas. -
 Encontró un hongo capaz de inhibir el crecimiento de una bacteria. Este hongo fue identificado más adelante como Penicilliton chrysogemon, que Fleming denominó penicilina a este inhibidor activo de los hongos. Por lo tanto la penicilina es un antibiótico producido por un hongo. Su enorme utilidad no se evidenció hasta la década de 1940, cuando por fin fue evaluada en ensayos clínicos producidos en forma masiva.
Encontró un hongo capaz de inhibir el crecimiento de una bacteria. Este hongo fue identificado más adelante como Penicilliton chrysogemon, que Fleming denominó penicilina a este inhibidor activo de los hongos. Por lo tanto la penicilina es un antibiótico producido por un hongo. Su enorme utilidad no se evidenció hasta la década de 1940, cuando por fin fue evaluada en ensayos clínicos producidos en forma masiva. -
 Propuso la clasificación de los estreptococos según serotipos, sobre la base de cientos componentes de la pared celular de las bacterias. Los estreptocococos causan una diversidad de enfermedades, como angina, shock tóxico estreptocócico y septicemia. Su investigación permite la identificación rápida de estreptococos patógenos específicos por medio de técnicas inmunológicas.
Propuso la clasificación de los estreptococos según serotipos, sobre la base de cientos componentes de la pared celular de las bacterias. Los estreptocococos causan una diversidad de enfermedades, como angina, shock tóxico estreptocócico y septicemia. Su investigación permite la identificación rápida de estreptococos patógenos específicos por medio de técnicas inmunológicas. -
 Demostró que el microorganismo denominado virus del mosaico del tabaco presentaba características muy diferentes de las de otros microorganismos y era tan simple y homogéneo que podía ser cristalizado como si fuera un compuesto químico.
Demostró que el microorganismo denominado virus del mosaico del tabaco presentaba características muy diferentes de las de otros microorganismos y era tan simple y homogéneo que podía ser cristalizado como si fuera un compuesto químico. -
 Demostraron la relación entre genes y enzimas.
Demostraron la relación entre genes y enzimas. -
 Propusieron un modelo de la estructura y la replicación del ADN. En 1960 se produjo una nueva explosión de descubrimientos relacionados con el modo en que el ADN controla la síntesis de proteínas.
Propusieron un modelo de la estructura y la replicación del ADN. En 1960 se produjo una nueva explosión de descubrimientos relacionados con el modo en que el ADN controla la síntesis de proteínas. -
 Establecieron que el ADN era el material genético.
Establecieron que el ADN era el material genético. -
 Descubrieron que el material genético podía transferirse de una bacteria a otra mediante un proceso denominado conjugación.
Descubrieron que el material genético podía transferirse de una bacteria a otra mediante un proceso denominado conjugación. -
 Descubrieron el ARN mensajero, una sustancia quimica implicada en la síntesis proteica y con posterioridad realizaron las primeras observaciones importantes sobre la regulación del funcionamiento de los genes de las bacterias
Descubrieron el ARN mensajero, una sustancia quimica implicada en la síntesis proteica y con posterioridad realizaron las primeras observaciones importantes sobre la regulación del funcionamiento de los genes de las bacterias -
 El virus de Epstein-Barr (EBV) es un virus del herpes γ humano. Es el agente causante de enfermedades como la Mononucleosis Infecciosa y se asocia a varios síndromes inmunoproliferativos. A diferencia de otros virus del herpes, como el herpes simple, no existe un tratamiento contra el VEB.
El virus de Epstein-Barr (EBV) es un virus del herpes γ humano. Es el agente causante de enfermedades como la Mononucleosis Infecciosa y se asocia a varios síndromes inmunoproliferativos. A diferencia de otros virus del herpes, como el herpes simple, no existe un tratamiento contra el VEB. -
 Descubrimientos realizados por dos microbiologos, constituyeron la base del conocimiento actual de los ciclos bioquimicos que mantienen la vida sobre la tierra. Mantinus Beijetinck y Sergel Winograsky fueron los primeros en demostrar que las bacterias constribuyen al reciclado de elementos vitales entre el suelo y la atmósfero. La ecología microbiana, el estudio de los microorganismos y su ambiente.
Descubrimientos realizados por dos microbiologos, constituyeron la base del conocimiento actual de los ciclos bioquimicos que mantienen la vida sobre la tierra. Mantinus Beijetinck y Sergel Winograsky fueron los primeros en demostrar que las bacterias constribuyen al reciclado de elementos vitales entre el suelo y la atmósfero. La ecología microbiana, el estudio de los microorganismos y su ambiente. -
 Propuso la clasificación biológica que clasifica el árbol de la vida en tres grupos, en la categoría más alta: Bacteria (en sentido restringido, excluyendo a las arqueas, a diferencia de la hasta en ese momento concepción del grupo), Archaea y Eukarya. Woese se basó en las diferencias encontradas en la secuencia del ARN ribosomal de la subunidad menor, para concluir que estos grupos se desarrollaron por separado de un progenitor común llamado progenote.
Propuso la clasificación biológica que clasifica el árbol de la vida en tres grupos, en la categoría más alta: Bacteria (en sentido restringido, excluyendo a las arqueas, a diferencia de la hasta en ese momento concepción del grupo), Archaea y Eukarya. Woese se basó en las diferencias encontradas en la secuencia del ARN ribosomal de la subunidad menor, para concluir que estos grupos se desarrollaron por separado de un progenitor común llamado progenote. -
 Estructura. El virus del mosaico del tabaco tiene una apariencia de varilla. Su cápside está hecha de 2130 moléculas de proteína de recubrimiento y una molécula de ARN genómico de una sola hebra, de 6400 bases de largo.
Estructura. El virus del mosaico del tabaco tiene una apariencia de varilla. Su cápside está hecha de 2130 moléculas de proteína de recubrimiento y una molécula de ARN genómico de una sola hebra, de 6400 bases de largo. -

-
 Descubrió una bacteria lo suficientemente grande como para ser observada a simple vista (o,2mm de ancho). Esta bacteria denominada Thiomargarita nomibiensis, vive en el lodo de las costas africanas, consume sulfuro de hidrógeno, que podría ser tóxico para los animales que residen en el lugar.
Descubrió una bacteria lo suficientemente grande como para ser observada a simple vista (o,2mm de ancho). Esta bacteria denominada Thiomargarita nomibiensis, vive en el lodo de las costas africanas, consume sulfuro de hidrógeno, que podría ser tóxico para los animales que residen en el lugar.
Plan projects on a visual timeline
Map milestones, phases, deadlines, and key events in one place so the sequence is easier to see and share. Timetoast is a timeline maker for work, school, research, and stories.